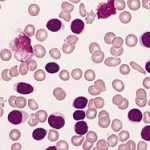

HEPATITIS B INFECTION
November 6, 2022
CHRONIC LYMPHOCYTIC LEUKAEMIA
November 12, 2022Toxoplasmosis is caused by infection with the protozoan Toxoplasma gondii. The parasite is found in cat faeces and contaminated food. It can cause serious complications for pregnant women and people with weakened immune systems. The disease usually resolves itself.
The transmission of Toxoplasmosis can be Food-borne, Zoonotic, Congenital or in rare instances. Food-borne methods of transmission are through contaminated food, drinks, kitchen tools, fruits and vegetables. Zoonotic transmission is through contact with cat faeces. The congenital means of transmission occur when an infant is birthed by an infected mother. The rare means of transmission is by infected organ transplant or blood products (unclean needles or unscreened blood).
The risk factors are being infected with HIV/AIDS, chemotherapy treatment for cancer, high-dose steroids, infants born to infected mothers and drugs that suppress immunity.
Symptoms of Toxoplasmosis are fever, headache, muscle aches, skin rash, slow growth, swollen lymph nodes, heart disorder, poor coordination, hearing loss, sore throat, mental problems, seizures, jaundice, poor vision and blindness.
The complications of Toxoplasmosis are cerebral toxoplasmosis, pneumonitis and ocular toxoplasmosis.
The diagnosis of toxoplasmosis is typically made by serologic or molecular testing of Toxoplasmic gondii (IgM and IgG) in the blood, tissue biopsy, microscopic examination and isolation of parasites in the blood, CSF and stool.
Mild infections do not need treatment. Meanwhile, drugs may be needed for serious cases, pregnant people, newborns and immunosuppressed individuals.
The spread of toxoplasmosis can be prevented by wearing gloves when handling gloves, avoiding raw meats, washing kitchen utensils thoroughly, washing all fruits and vegetables, proper hand washing and avoiding untreated water and unpasteurized goat milk.
Visit MedBioTech for an accurate diagnosis of Toxoplasmosis.
REFERENCES:
emedicine.medscape.com
www.cdc.gov
www.healthline.com
www.mayoclinic.org


